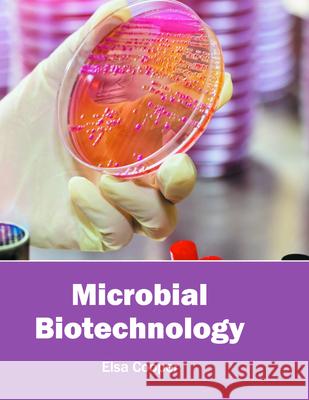
Microbial Biotechnology Elsa Cooper 9781682860977 Syrawood Publishing House

» książki » Science - Biotechnology
 |
The Stem Cell: " Its Revolutionary Impact & Controversy "
ISBN: 9781523794478 / Angielski / Miękka / 220 str. Termin realizacji zamówienia: ok. 5-8 dni roboczych. Stem cells are undifferentiated biological cells that can differentiate into specialized cells and can divide (through mitosis) to produce more stem cells. They are found in multicellular organisms. In mammals, there are two broad types of stem cells: embryonic stem cells, which are isolated from the inner cell mass of blastocysts, and adult stem cells, which are found in various tissues. In adult organisms, stem cells and progenitor cells act as a repair system for the body, replenishing adult tissues. In a developing embryo, stem cells can differentiate into all the specialized...
Stem cells are undifferentiated biological cells that can differentiate into specialized cells and can divide (through mitosis) to produce more stem c...
|
cena:
78,52 |
 |
Optical Tweezers: Methods and Protocols
ISBN: 9781493964192 / Angielski / Twarda / 555 str. Termin realizacji zamówienia: ok. 5-8 dni roboczych. The aim of this volume is to provide a comprehensive overview of optical tweezers setups, both in practical and theoretical terms, to help biophysicists, biochemists, and cell biologists to build and calibrate their own instruments and to perform force measurements on mechanoenzymes both in isolation in vitro and in living cells. Chapters have been divided in three parts focusing on theory and practical design of optical tweezers, detailed protocols for performing force measurements on single DNA- and microtubule/actin-associated mechanoenzymes in isolation, and describing recent... The aim of this volume is to provide a comprehensive overview of optical tweezers setups, both in practical and theoretical terms, to help biophysi... |
cena:
644,07 |
 |
Research in Biotechnology
ISBN: 9781530478590 / Angielski / Miękka / 68 str. Termin realizacji zamówienia: ok. 5-8 dni roboczych. Welcome to the first edition of the Rock Canyon High School Research in Biotechnology Journal, a product of the the Principles of Experimental Design in Biotechnology class at Rock Canyon High School in Highlands Ranch, Colorado. Students conducted authentic scientific research from start to finish: designing their research experiments, finding an expert mentor in the field, writing and defending a research proposal, writing a budget and securing their own sources of funding, ordering their materials, conducting research, making a scientific poster, presenting at a research symposium, and...
Welcome to the first edition of the Rock Canyon High School Research in Biotechnology Journal, a product of the the Principles of Experimental Design ...
|
cena:
70,84 |
 |
The Ethics and Biosecurity Toolkit for Scientists
ISBN: 9781786340917 / Angielski / Twarda / 332 str. Termin realizacji zamówienia: ok. 5-8 dni roboczych. This book is designed to be an easy-to-use guide to understanding the ethical and biosecurity implications of life science research. It provides a framework that will enable scientists, lab managers, researchers, students and teachers to anticipate how research may be used to cause harm, and to identify the steps that can be taken to minimise this risk.Life science research is covered by two international weapons treaties and the tools presented in this book will help scientists and researchers to meet their responsibilities under these conventions. This book will help you: If you've never...
This book is designed to be an easy-to-use guide to understanding the ethical and biosecurity implications of life science research. It provides a fra...
|
cena:
317,06 |
 |
The Ethics and Biosecurity Toolkit for Scientists
ISBN: 9781786340924 / Angielski / Miękka / 332 str. Termin realizacji zamówienia: ok. 5-8 dni roboczych. This book is designed to be an easy-to-use guide to understanding the ethical and biosecurity implications of life science research. It provides a framework that will enable scientists, lab managers, researchers, students and teachers to anticipate how research may be used to cause harm, and to identify the steps that can be taken to minimise this risk.Life science research is covered by two international weapons treaties and the tools presented in this book will help scientists and researchers to meet their responsibilities under these conventions. This book will help you: If you've never...
This book is designed to be an easy-to-use guide to understanding the ethical and biosecurity implications of life science research. It provides a fra...
|
cena:
156,09 |
 |
White Biotechnology
ISBN: 9781682860601 / Angielski / Twarda / 211 str. Termin realizacji zamówienia: ok. 5-8 dni roboczych. |
cena:
543,49 |
|
Microbial Biotechnology
ISBN: 9781682860977 / Angielski / Twarda / 216 str. Termin realizacji zamówienia: ok. 5-8 dni roboczych. |
cena:
543,49 |
 |
Principles and Practices of Nanobiotechnology
ISBN: 9781682861103 / Angielski / Twarda / 217 str. Termin realizacji zamówienia: ok. 5-8 dni roboczych. |
cena:
543,49 |
 |
Nanobiosciences: Current Techniques and Applications
ISBN: 9781682861424 / Angielski / Twarda / 217 str. Termin realizacji zamówienia: ok. 5-8 dni roboczych. |
cena:
543,49 |
 |
Principles, Techniques and Practices of Biotechnology
ISBN: 9781682861905 / Angielski / Twarda / 233 str. Termin realizacji zamówienia: ok. 5-8 dni roboczych. Biotechnology is a fast developing field of research and its applications are finding more and more relevance with the passage of time. From stem cell research to applications in agriculture and medical science, the scope of biotechnology is vast. The topics included in this book like - food and bioprocessing, bioengineering, immobilization, biotechnology, etc. are of utmost significance and are bound to provide incredible insights to readers. This text elucidates the concepts and innovative models around prospective developments with respect to biotechnology. It will benefit...
Biotechnology is a fast developing field of research and its applications are finding more and more relevance with the passage of time. From stem cell...
|
cena:
562,23 |
 |
Textbook of Biotechnology
ISBN: 9781682861943 / Angielski / Twarda / 233 str. Termin realizacji zamówienia: ok. 5-8 dni roboczych. |
cena:
562,23 |
 |
Bioprocess Engineering
ISBN: 9781682861950 / Angielski / Twarda / 235 str. Termin realizacji zamówienia: ok. 5-8 dni roboczych. |
cena:
562,23 |
 |
Bioprocessing and Biotechnology
ISBN: 9781682862070 / Angielski / Twarda / 250 str. Termin realizacji zamówienia: ok. 5-8 dni roboczych. |
cena:
580,98 |
 |
Red Biotechnology
ISBN: 9781682862100 / Angielski / Twarda / 253 str. Termin realizacji zamówienia: ok. 5-8 dni roboczych. |
cena:
580,98 |
 |
Bioresource Technology: Concepts, Design and Applications
ISBN: 9781682862261 / Angielski / Twarda / 256 str. Termin realizacji zamówienia: ok. 5-8 dni roboczych. |
cena:
580,98 |
 |
Industrial Biotechnology
ISBN: 9781682862339 / Angielski / Twarda / 262 str. Termin realizacji zamówienia: ok. 5-8 dni roboczych. |
cena:
580,98 |
 |
Analytical Techniques in Biotechnology
ISBN: 9781682862384 / Angielski / Twarda / 264 str. Termin realizacji zamówienia: ok. 5-8 dni roboczych. |
cena:
573,48 |
 |
Bioengineering
ISBN: 9781682862759 / Angielski / Twarda / 268 str. Termin realizacji zamówienia: ok. 5-8 dni roboczych. |
cena:
573,48 |
 |
Integrated Biotechnology: Principles and Practices
ISBN: 9781682863121 / Angielski / Twarda / 279 str. Termin realizacji zamówienia: ok. 5-8 dni roboczych. |
cena:
580,98 |
 |
Green Biotechnology and Allied Fields
ISBN: 9781682863220 / Angielski / Twarda / 278 str. Termin realizacji zamówienia: ok. 5-8 dni roboczych. |
cena:
580,98 |













